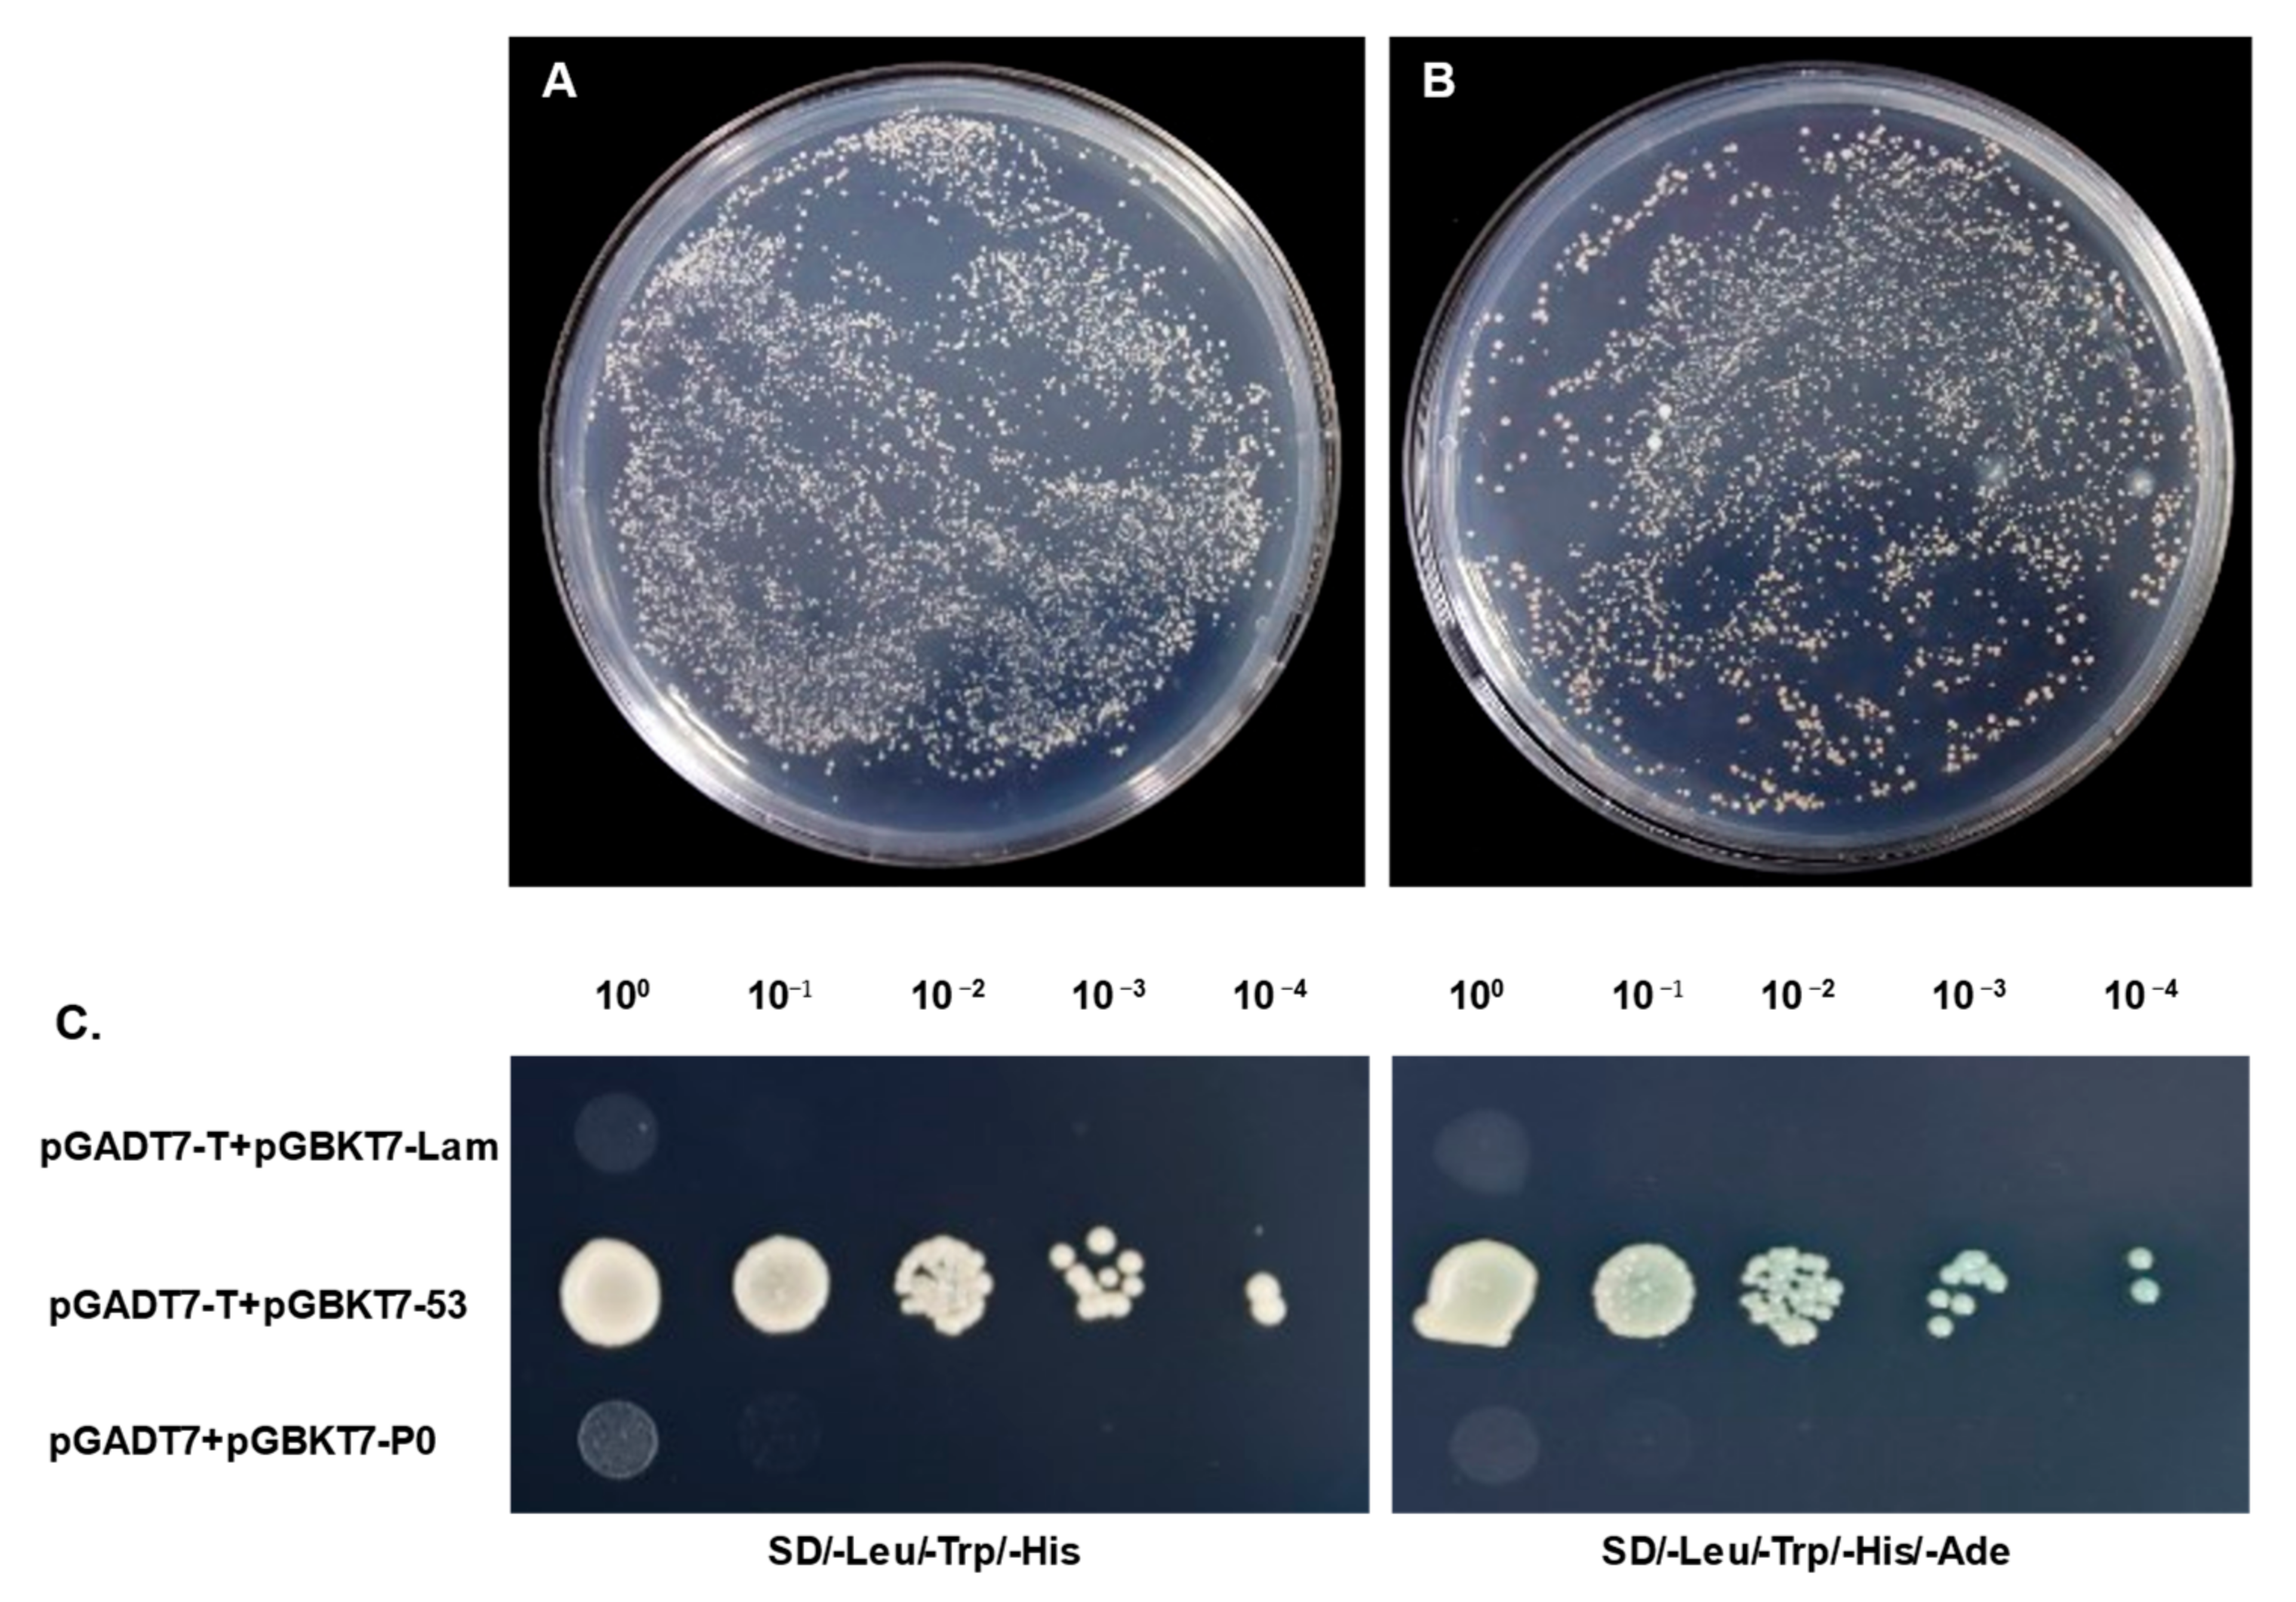
Genes 14 01397 g003 Genes 14 01397 g003

Screening and Identification of Host Factors Interacting with the Virulence Factor P0 Encoded by Sugarcane Yellow Leaf Virus by Yeast Two-Hybrid Assay
Abstract
1. Introduction
2. Materials and Methods
2.1. Sequence Analysis
2.2. Plant Materials and Growth Conditions
2.3. Plasmid Construction
2.4. Agroinfiltration Assays
2.5. H2O2 Detection in Plants
2.6. Protein Extraction and Western Blot analysis
2.7. cDNA Expression Library Construction and Quality Assay
2.8. Assays of Auto-Activation and Toxicity of the Bait Plasmid
2.9. Yeast Two-Hybrid Screening with Co-Transformation
2.10. Validation of the Screened Interactions
2.11. Function Analysis of True Positive Prey
3. Results
3.1. Phylogenetic Analyses and Domain Architecture of Sugarcane-Yellow-Leaf-Virus-Encoded P0
3.2. P0 Is a Virulence Determinant and Elicits a Hypersensitive-Like Response (HLR) in N. benthamiana
3.3. Construction of cDNA Library and pGBKT7-P0 Bait Plasmid
3.4. Assay Results of Auto-Activation and Toxicity of the Bait Plasmid
3.5. Yeast Two-Hybrid Screening and Confirmation of the Interactions between pGBKT7-P0 and Screened Prey Plasmids
3.6. Sequencing and Analysis of Confirmed True Positive Prey Plasmids
4. Discussion
5. Conclusions
Supplementary Materials
Author Contributions
Funding
Institutional Review Board Statement
Informed Consent Statement
Data Availability Statement
Conflicts of Interest
References
- Smith, G.R.; Borg, Z.; Lockhart, B.E.L.; Braithwaite, K.S.; Gibbs, M.J. Sugarcane yellow leaf virus: A novel member of the Luteoviridae that probably arose by inter-species recombination. Microbiology 2000, 81, 1865–1869. [Google Scholar] [CrossRef] [PubMed]
- Vega, J.; Scagliusi, S.M.; Ulian, E.C. Sugarcane Yellow Leaf Disease in Brazil: Evidence of Association with a Luteovirus. Plant Dis. 1997, 81, 21–26. [Google Scholar] [CrossRef] [PubMed]
- Mangwende, T.; Wang, M.-L.; Borth, W.; Hu, J.; Moore, P.H.; Mirkov, T.E.; Albert, H.H. The P0 gene of Sugarcane yellow leaf virus encodes an RNA silencing suppressor with unique activities. Virology 2009, 384, 38–50. [Google Scholar] [CrossRef] [PubMed]
- Abu Ahmad, Y.; Rassaby, L.; Royer, M.; Borg, Z.; Braithwaite, K.S.; Mirkov, T.E.; Irey, M.S.; Perrier, X.; Smith, G.R.; Rott, P. Yellow leaf of sugarcane is caused by at least three different genotypes of sugarcane yellow leaf virus, one of which predominates on the Island of Réunion. Arch. Virol. 2006, 151, 1355–1371. [Google Scholar] [CrossRef] [PubMed]
- Delfosse, V.C.; Agrofoglio, Y.C.; Casse, M.F.; Kresic, I.B.; Hopp, H.E.; Ziegler-Graff, V.; Distéfano, A.J. The P0 protein encoded by cotton leafroll dwarf virus (CLRDV) inhibits local but not systemic RNA silencing. Virus Res. 2014, 180, 70–75. [Google Scholar] [CrossRef]
- Han, Y.-H.; Xiang, H.-Y.; Wang, Q.; Li, Y.-Y.; Wu, W.-Q.; Han, C.-G.; Li, D.-W.; Yu, J.-L. Ring structure amino acids affect the suppressor activity of melon aphid-borne yellows virus P0 protein. Virology 2010, 406, 21–27. [Google Scholar] [CrossRef]
- Kozlowska-Makulska, A.; Guilley, H.; Szyndel, M.S.; Beuve, M.; Lemaire, O.; Herrbach, E.; Bouzoubaa, S. P0 proteins of European beet-infecting poleroviruses display variable RNA silencing suppression activity. J. Gen. Virol. 2010, 91, 1082–1091. [Google Scholar] [CrossRef]
- Mayo, M.A.; Ziegler-Graff, V. Molecular Biology of Luteoviruses. In Advances in Virus Research; Elsevier: Amsterdam, The Netherlands, 1996; Volume 46, pp. 413–460. ISBN 978-0-12-039846-1. [Google Scholar]
- Sadowy, E.; Maasen, A.; Juszczuk, M.; David, C.; Zagórski-Ostoja, W.; Gronenborn, B.; Hulanicka, M.D. The ORF0 product of Potato leafroll virus is indispensable for virus accumulation. J. Gen. Virol. 2001, 82, 1529–1532. [Google Scholar] [CrossRef]
- Pazhouhandeh, M.; Dieterle, M.; Marrocco, K.; Lechner, E.; Berry, B.; Brault, V.; Hemmer, O.; Kretsch, T.; Richards, K.E.; Genschik, P.; et al. F-box-like domain in the polerovirus protein P0 is required for silencing suppressor function. Proc. Natl. Acad. Sci. USA 2006, 103, 1994–1999. [Google Scholar] [CrossRef]
- Baumberger, N.; Tsai, C.-H.; Lie, M.; Havecker, E.; Baulcombe, D.C. The Polerovirus Silencing Suppressor P0 Targets ARGONAUTE Proteins for Degradation. Curr. Biol. 2007, 17, 1609–1614. [Google Scholar] [CrossRef]
- Bortolamiol, D.; Pazhouhandeh, M.; Marrocco, K.; Genschik, P.; Ziegler-Graff, V. The Polerovirus F Box Protein P0 Targets ARGONAUTE1 to Suppress RNA Silencing. Curr. Biol. 2007, 17, 1615–1621. [Google Scholar] [CrossRef]
- Zhuo, T.; Li, Y.-Y.; Xiang, H.-Y.; Wu, Z.-Y.; Wang, X.-B.; Wang, Y.; Zhang, Y.-L.; Li, D.-W.; Yu, J.-L.; Han, C.-G. Amino Acid Sequence Motifs Essential for P0-Mediated Suppression of RNA Silencing in an Isolate of Potato leafroll virus from Inner Mongolia. Mol. Plant-Microbe Interact. 2014, 27, 515–527. [Google Scholar] [CrossRef] [PubMed]
- Csorba, T.; Lózsa, R.; Hutvágner, G.; Burgyán, J. Polerovirus protein P0 prevents the assembly of small RNA-containing RISC complexes and leads to degradation of ARGONAUTE1. Plant J. 2010, 62, 463–472. [Google Scholar] [CrossRef] [PubMed]
- Derrien, B.; Baumberger, N.; Schepetilnikov, M.; Viotti, C.; De Cillia, J.; Ziegler-Graff, V.; Isono, E.; Schumacher, K.; Genschik, P. Degradation of the antiviral component ARGONAUTE1 by the autophagy pathway. Proc. Natl. Acad. Sci. USA 2012, 109, 15942–15946. [Google Scholar] [CrossRef]
- Fusaro, A.F.; Correa, R.L.; Nakasugi, K.; Jackson, C.; Kawchuk, L.; Vaslin, M.F.S.; Waterhouse, P.M. The Enamovirus P0 protein is a silencing suppressor which inhibits local and systemic RNA silencing through AGO1 degradation. Virology 2012, 426, 178–187. [Google Scholar] [CrossRef] [PubMed]
- Levine, A.; Pennell, R.I.; Alvarez, M.E.; Palmer, R.; Lamb, C. Calcium-mediated apoptosis in a plant hypersensitive disease resistance response. Curr. Biol. 1996, 6, 427–437. [Google Scholar] [CrossRef] [PubMed]
- Mozo, T.; Hooykaas, P.J.J. Electroporation of megaplasmids into Agrobacterium. Plant Mol. Biol. 1991, 16, 917–918. [Google Scholar] [CrossRef]
- Voinnet, O.; Vain, P.; Angell, S.; Baulcombe, D.C. Systemic Spread of Sequence-Specific Transgene RNA Degradation in Plants Is Initiated by Localized Introduction of Ectopic Promoterless DNA. Cell 1998, 95, 177–187. [Google Scholar] [CrossRef]
- Sharma, P.; Ikegami, M. Tomato leaf curl Java virus V2 protein is a determinant of virulence, hypersensitive response and suppression of posttranscriptional gene silencing. Virology 2010, 396, 85–93. [Google Scholar] [CrossRef]
- Li, P.; Su, F.; Meng, Q.; Yu, H.; Wu, G.; Li, M.; Qing, L. The C5 protein encoded by Ageratum leaf curl Sichuan virus is a virulence factor and contributes to the virus infection. Mol. Plant Pathol. 2021, 22, 1149–1158. [Google Scholar] [CrossRef]
- Li, P.; Guo, L.; Lang, X.; Li, M.; Wu, G.; Wu, R.; Wang, L.; Zhao, M.; Qing, L. Geminivirus C4 proteins inhibit GA signaling via prevention of NbGAI degradation, to promote viral infection and symptom development in N. benthamiana. PLoS Pathog. 2022, 18, e1010217. [Google Scholar] [CrossRef]
- Zhao, S.; Gong, P.; Ren, Y.; Liu, H.; Li, H.; Li, F.; Zhou, X. The novel C5 protein from tomato yellow leaf curl virus is a virulence factor and suppressor of gene silencing. Stress Biol. 2022, 2, 19. [Google Scholar] [CrossRef]
- Hussain, M.; Mansoor, S.; Iram, S.; Zafar, Y.; Briddon, R.W. The Hypersensitive Response to Tomato leaf curl New Delhi virus Nuclear Shuttle Protein Is Inhibited by Transcriptional Activator Protein. Mol. Plant-Microbe Interact. 2007, 20, 1581–1588. [Google Scholar] [CrossRef] [PubMed]
- Kim, C.; Park, J.; Choi, G.; Kim, S.; Vo, K.T.X.; Jeon, J.; Kang, S.; Lee, Y. A rice gene encoding glycosyl hydrolase plays contrasting roles in immunity depending on the type of pathogens. Mol. Plant Pathol. 2022, 23, 400–416. [Google Scholar] [CrossRef] [PubMed]
- Gonçalves, M.C.; Vega, J.; Oliveira, J.G.; Gomes, M.M.A. Sugarcane yellow leaf virus infection leads to alterations in photosynthetic efficiency and carbohydrate accumulation in sugarcane leaves. Fitopatol. Bras. 2005, 30, 10–16. [Google Scholar] [CrossRef]
- Yan, S.-L.; Lehrer, A.T.; Hajirezaei, M.R.; Springer, A.; Komor, E. Modulation of carbohydrate metabolism and chloroplast structure in sugarcane leaves which were infected by Sugarcane Yellow Leaf Virus (SCYLV). Physiol. Mol. Plant Pathol. 2008, 73, 78–87. [Google Scholar] [CrossRef]
- Dobnik, D.; Baebler, Š.; Kogovšek, P.; Pompe-Novak, M.; Štebih, D.; Panter, G.; Janež, N.; Morisset, D.; Žel, J.; Gruden, K. β-1,3-glucanase class III promotes spread of PVYNTN and improves in planta protein production. Plant Biotechnol. Rep. 2013, 7, 547–555. [Google Scholar] [CrossRef]
- Zavaliev, R.; Ueki, S.; Epel, B.L.; Citovsky, V. Biology of callose (β-1,3-glucan) turnover at plasmodesmata. Protoplasma 2011, 248, 117–130. [Google Scholar] [CrossRef]
- Wu, J.; Yang, R.; Yang, Z.; Yao, S.; Zhao, S.; Wang, Y.; Li, P.; Song, X.; Jin, L.; Zhou, T.; et al. ROS accumulation and antiviral defence control by microRNA528 in rice. Nat. Plants 2017, 3, 16203. [Google Scholar] [CrossRef]
- Kumari, R.; Kumar, S.; Singh, L.; Hallan, V. Movement Protein of Cucumber Mosaic Virus Associates with Apoplastic Ascorbate Oxidase. PLoS ONE 2016, 11, e0163320. [Google Scholar] [CrossRef]
- Thivierge, K.; Cotton, S.; Dufresne, P.J.; Mathieu, I.; Beauchemin, C.; Ide, C.; Fortin, M.G.; Laliberté, J.-F. Eukaryotic elongation factor 1A interacts with Turnip mosaic virus RNA-dependent RNA polymerase and VPg-Pro in virus-induced vesicles. Virology 2008, 377, 216–225. [Google Scholar] [CrossRef] [PubMed]
- Zeenko, V.V.; Ryabova, L.A.; Spirin, A.S.; Rothnie, H.M.; Hess, D.; Browning, K.S.; Hohn, T. Eukaryotic Elongation Factor 1A Interacts with the Upstream Pseudoknot Domain in the 3′ Untranslated Region of Tobacco Mosaic Virus RNA. J. Virol. 2002, 76, 5678–5691. [Google Scholar] [CrossRef] [PubMed]

Disclaimer/Publisher’s Note: The statements, opinions and data contained in all publications are solely those of the individual author(s) and contributor(s) and not of MDPI and/or the editor(s). MDPI and/or the editor(s) disclaim responsibility for any injury to people or property resulting from any ideas, methods, instructions or products referred to in the content. |
© 2023 by the authors. Licensee MDPI, Basel, Switzerland. This article is an open access article distributed under the terms and conditions of the Creative Commons Attribution (CC BY) license (https://creativecommons.org/licenses/by/4.0/).
Share and Cite
Liang, K.-L.; Liu, J.-Y.; Bao, Y.-Y.; Wang, Z.-Y.; Xu, X.-B. Screening and Identification of Host Factors Interacting with the Virulence Factor P0 Encoded by Sugarcane Yellow Leaf Virus by Yeast Two-Hybrid Assay. Genes 2023, 14, 1397. https://doi.org/10.3390/genes14071397
Liang K-L, Liu J-Y, Bao Y-Y, Wang Z-Y, Xu X-B. Screening and Identification of Host Factors Interacting with the Virulence Factor P0 Encoded by Sugarcane Yellow Leaf Virus by Yeast Two-Hybrid Assay. Genes. 2023; 14(7):1397. https://doi.org/10.3390/genes14071397
Chicago/Turabian StyleLiang, Kai-Li, Jing-Ying Liu, Ying-Ying Bao, Zhi-Yuan Wang, and Xiong-Biao Xu. 2023. "Screening and Identification of Host Factors Interacting with the Virulence Factor P0 Encoded by Sugarcane Yellow Leaf Virus by Yeast Two-Hybrid Assay" Genes 14, no. 7: 1397. https://doi.org/10.3390/genes14071397
APA StyleLiang, K.-L., Liu, J.-Y., Bao, Y.-Y., Wang, Z.-Y., & Xu, X.-B. (2023). Screening and Identification of Host Factors Interacting with the Virulence Factor P0 Encoded by Sugarcane Yellow Leaf Virus by Yeast Two-Hybrid Assay. Genes, 14(7), 1397. https://doi.org/10.3390/genes14071397

